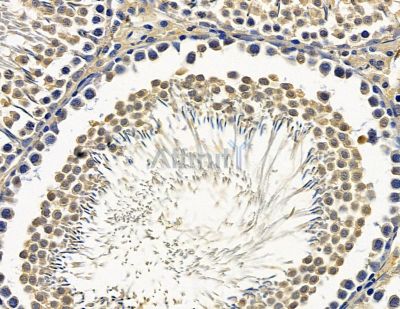
ZNF365 Antibody - DF15561 at 1/100 staining rat testis tissue by IHC-P.

ZNF365 Antibody - #DF15561
Related Downloads
Protocols
Product Info
Source:
Rabbit
Application:
IHC 1:50-1:200, WB 1:500-1:2000
*The optimal dilutions should be determined by the end user. For optimal experimental results, antibody reuse is not recommended.
*Tips:
*The optimal dilutions should be determined by the end user. For optimal experimental results, antibody reuse is not recommended.
*Tips:
WB: For western blot detection of denatured protein samples. IHC: For immunohistochemical detection of paraffin sections (IHC-p) or frozen sections (IHC-f) of tissue samples. IF/ICC: For immunofluorescence detection of cell samples. ELISA(peptide): For ELISA detection of antigenic peptide.
Reactivity:
Human,Mouse,Rat
Clonality:
Polyclonal
Specificity:
ZNF365 Antibody detects endogenous levels of ZNF365.
Conjugate:
Unconjugated.
Purification:
The antiserum was purified by peptide affinity chromatography using SulfoLink™ Coupling Resin (Thermo Fisher Scientific).
Storage:
Rabbit IgG in phosphate buffered saline, pH 7.4, 150mM NaCl, 0.02% sodium azide and 50% glycerol. Store at -20 °C. Stable for 12 months from date of receipt.
Immunogens
Immunogen:
A synthesized peptide derived from human ZNF365.
Uniprot:
Gene(ID):
Expression:
Sequence:
- Q70YC4 TALAN_HUMAN:
- Protein BLAST With
- NCBI/
- ExPASy/
- Uniprot
MSALGQITITVSRCWNTERNQTDKNPCLHGAYLQLRETVKNKSTHLKKPLMKQAPPWKDHLTFQPLHPAERKTQVWRWQSGNSSDLETTSSASPWPTGSNRDVVLNTLAESCCGLSELITAPPYAGVSIQGFSQIWVLFPFCGGTFHHNEKDVLGLQDFERESVSTSQSRNISLLTLGQLQNCVIGKLTIIDLLTEHLLGVRHGVICFPWGLPSSS
Research Backgrounds
Function:
May play a role in uric acid excretion.
Tissue Specificity:
Isoform 4 is expressed in placenta, lung, kidney and pancreas.
References
1). Reduced Proliferative Capacity and Defense against Staphylococcus aureus in Human Nasal Mucosal Epithelium Lacking ZNF365. International archives of allergy and immunology, 2024
(PubMed: 38354721)
[IF=2.5]
Restrictive clause
Affinity Biosciences tests all products strictly. Citations are provided as a resource for additional applications that have not been validated by Affinity Biosciences. Please choose the appropriate format for each application and consult Materials and Methods sections for additional details about the use of any product in these publications.
For Research Use Only.
Not for use in diagnostic or therapeutic procedures. Not for resale. Not for distribution without written consent. Affinity Biosciences will not be held responsible for patent infringement or other violations that may occur with the use of our products. Affinity Biosciences, Affinity Biosciences Logo and all other trademarks are the property of Affinity Biosciences LTD.